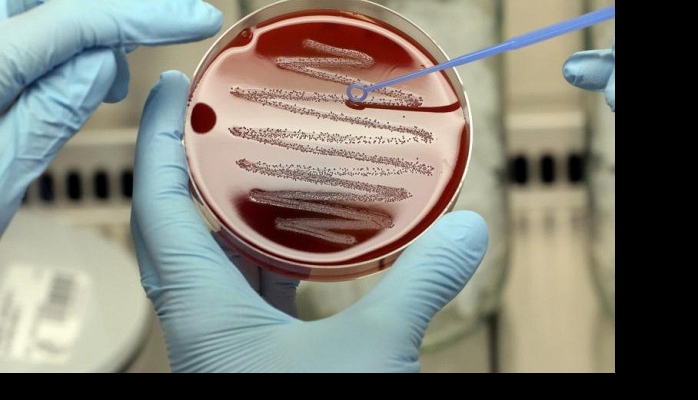

Впервые в истории науки ученые смогли обнаружить генетические вариации, связанные с обретением смысла…
Исследователи из Нидерландов впервые в истории обнаружили в человеческом геноме места, которые определяют и могут объяснять различия в понимании смысла жизни. Таковы результаты исследования с участием более 220 тысяч человек. Авторы исследования идентифицировали две генетические вариации, влияющие на смысл жизни, и ещё шесть вариантов генов, определяющих счастье.
Существование генетических вариантов для обретения смысла жизни доказывает, что различия между людьми в столь сложном когнитивном процессе частично объясняются биологическими факторами. Исследователи подчеркивают, что мы живём в обществе, где каждому необходимо преуспевать и достигать максимальных показателей, обретая осмысленное существование. Если же наука поймёт, что именно вызывает различия между людьми в этом вопросе, то подобную информацию можно использовать для помощи тем, кто чувствует себя менее счастливыми, тщетно пытаясь обрести тот самый смысл жизни.
Исследование также показало, что существуют внешние факторы, крайне важные для счастья, но не для смысла жизни, и наоборот. В будущем ученые хотели бы определить, какие внешние факторы отвечают за это несоответствие.
Источник: Rambler.ru










Комментарии
Показать комментарии Скрыть комментарии